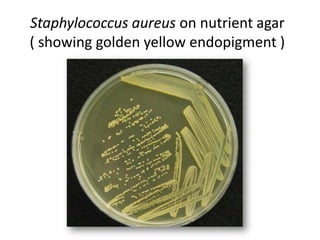
Staphylococcus aureus on nutrient agar
( showing golden yellow endopigment )
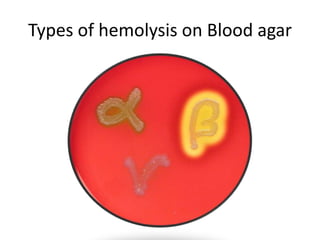
Types of hemolysis on Blood agar
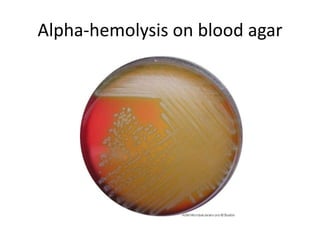
Alpha-hemolysis on blood agar
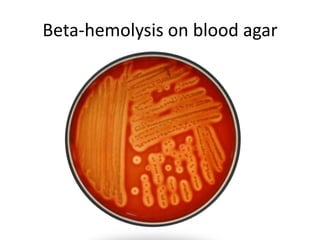
Beta-hemolysis on blood agar
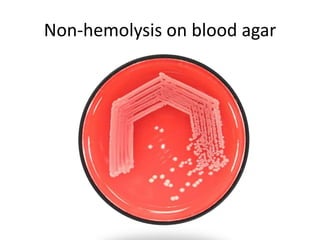
Non-hemolysis on blood agar
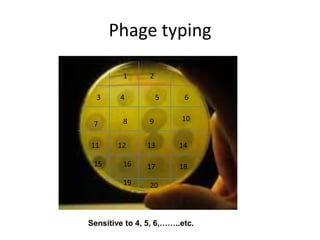
Phage typing
1 2
3 4 5 6
7 8 9 10
11 12 13 14
15 16 17 18
19 20
Sensitive to 4, 5, 6,……..etc.

This document contains slides and information about microbiological testing and identification of various bacteria and fungi. It includes schemes for staining bacteria with and without background staining. It also includes images of various microbes growing on different media like blood agar, chocolate agar and Loffler's serum. Various tests are described like coagulase testing of Staphylococcus, antibiotic sensitivity testing, phage typing and serological testing like Elek's test and tube agglutination testing.